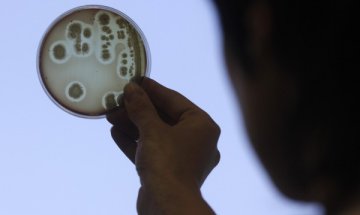
Създадоха тумор унищожаващи клетки

Японски учени обявиха, че са създали първите тумор унищожаващи клетки, които могат да бъдат директно инжектирани на пациенти.
Изследователите са създали тумор специфични Т-клетки убийци, за които се предполага, че след инжектиране в тялото в големи количества ще подсилят имунната система и ще й помогнат да елиминира туморите. Само по себе си това е сериозен научен пробив.
За създаването им, учените „препрограмират“ специализираните Т-лимфоцити в по-малко специализирани - плурипотентни стволови клетки. От последните те получават Т-лимфоцити, специализирани в елиминирането на определен вид тумори.
Това не е първият подобен експеримент. Успехът на този опит обаче, се състои в създаването на продължително живеещи клетки, което досега бе невъзможно и възпрепятстваше практическото приложение на този вид лечение.
Пробивът е постигнат след внимателно проучване на молекулните механизми и сигнали, чрез които плурипотентните стволови клетки се диференцират в специализирани Т-лимфоцити и изучаване на механизмите, чрез които това може да бъде контролирано и дори обръщано. Регресията на Т-лимфоцити до стволови клетки не се случва във възрастния организъм.
Следващата стъпка е да се провери в in vitro условия дали тези клетки наистина унищожават туморните без да поразяват нормалните на организма. Според изследователите, ако това наистина бъде потвърдено, до прилагането им на раково болни в клинични условия може да се достигне в сравнително кратки срокове.
Проучването е публикувано в сп. Cell Stem Cell.

Кадър на деня за 21 юни
Кадър на деня за 21 юни  Иран прекрати преговорите със САЩ след заплахите на Тръмп
Иран прекрати преговорите със САЩ след заплахите на Тръмп  САЩ засилват икономическата си война, но враговете не трепват
САЩ засилват икономическата си война, но враговете не трепват  Енергийният преход на Китай сега зависи от декарбонизацията на промишлеността
Енергийният преход на Китай сега зависи от декарбонизацията на промишлеността  Stellantis, Wayve Technologies и Uber се обединяват за масово навлизане на роботизирани таксита
Stellantis, Wayve Technologies и Uber се обединяват за масово навлизане на роботизирани таксита  Иран и САЩ започнаха преговори за постоянно мирно споразумение, Тръмп заплаши с нови удари
Иран и САЩ започнаха преговори за постоянно мирно споразумение, Тръмп заплаши с нови удари 
 Рецепта за тиквички с чесън и копър на тиган
Рецепта за тиквички с чесън и копър на тиган  Какво не знаем за траките и старите българи?
Какво не знаем за траките и старите българи?  Моторист загина в Русе
Моторист загина в Русе  Израел: "Хизбула" е в тежка ситуация след ударите
Израел: "Хизбула" е в тежка ситуация след ударите  Тръмп: Киър Стармър ще подаде оставка, провали се
Тръмп: Киър Стармър ще подаде оставка, провали се  Испания показа съвсем различно лице и разгроми Саудитска Арабия с 4:0
Испания показа съвсем различно лице и разгроми Саудитска Арабия с 4:0 
 Спортът по телевизията днес, 22 юни
Спортът по телевизията днес, 22 юни  Мачовете по телевизията днес, 22 юни
Мачовете по телевизията днес, 22 юни  Белгия пак се издъни, Иран едва не разплака „червените дяволи“
Белгия пак се издъни, Иран едва не разплака „червените дяволи“  ПО МИНУТИ: Белгия – Иран 0:0
ПО МИНУТИ: Белгия – Иран 0:0  Каспер Рууд вдигна тридневна сватба в Майорка + СНИМКИ
Каспер Рууд вдигна тридневна сватба в Майорка + СНИМКИ  Ямал: Планът беше да вкарам и... да си почина
Ямал: Планът беше да вкарам и... да си почина 
 Дневен хороскоп за 22 юни, понеделник
Дневен хороскоп за 22 юни, понеделник  Ястия за здраве и берекет на Еньовден
Ястия за здраве и берекет на Еньовден  Седмичен хороскоп за 22 – 28 юни: Хубав период за Рибите
Седмичен хороскоп за 22 – 28 юни: Хубав период за Рибите  3 ритуала, които сбъдват желания на Еньовден
3 ритуала, които сбъдват желания на Еньовден  Таро карти за юли за всяка зодия
Таро карти за юли за всяка зодия  Италианска рецепта за паста с чесън, моцарела и салчичон
Италианска рецепта за паста с чесън, моцарела и салчичон 
 продава, Многостаен апартамент, 110 m2 Пловдив, Христо Смирненски, 254999 EUR
продава, Многостаен апартамент, 110 m2 Пловдив, Христо Смирненски, 254999 EUR  продава, Етаж от къща, 110 m2 Пловдив, Христо Смирненски, 254999 EUR
продава, Етаж от къща, 110 m2 Пловдив, Христо Смирненски, 254999 EUR  продава, Двустаен апартамент, 79 m2 Пловдив, Въстанически, 129000 EUR
продава, Двустаен апартамент, 79 m2 Пловдив, Въстанически, 129000 EUR  продава, Двустаен апартамент, 82 m2 Пловдив, Тракия, 102388 EUR
продава, Двустаен апартамент, 82 m2 Пловдив, Тракия, 102388 EUR  продава, Тристаен апартамент, 108 m2 Пловдив, Христо Смирненски, 194472 EUR
продава, Тристаен апартамент, 108 m2 Пловдив, Христо Смирненски, 194472 EUR  продава, Тристаен апартамент, 102 m2 Пловдив, Христо Смирненски, 184230 EUR
продава, Тристаен апартамент, 102 m2 Пловдив, Христо Смирненски, 184230 EUR 
 Електромобилите с голям пробег се превръщат в проблем
Електромобилите с голям пробег се превръщат в проблем  Какво време ни очаква в понеделник?
Какво време ни очаква в понеделник?  Стрелба на плаж край Варна
Стрелба на плаж край Варна  Обърната кола стои в канавката край Кичево вече втори ден
Обърната кола стои в канавката край Кичево вече втори ден  Приключенец ще обиколи България с "Балканче" (ВИДЕО)
Приключенец ще обиколи България с "Балканче" (ВИДЕО)  Иван Иванов завърши втори на турнира в Ливърпул
Иван Иванов завърши втори на турнира в Ливърпул 
 Неочаквано откритие край Стоунхендж променя представите за древния монумент
Неочаквано откритие край Стоунхендж променя представите за древния монумент  Човешкият ум може да не е уникален: Учени стигнаха до необичайни заключения
Човешкият ум може да не е уникален: Учени стигнаха до необичайни заключения  След 100 години: Физици обясниха „най-голямата грешка“ на Айнщайн
След 100 години: Физици обясниха „най-голямата грешка“ на Айнщайн  С какво биха се хранили извънземните на Земята?
С какво биха се хранили извънземните на Земята?  В Албания намериха уникално светилище на забравени богове
В Албания намериха уникално светилище на забравени богове  Откриха нов клас древни космически обекти в Млечния път
Откриха нов клас древни космически обекти в Млечния път 












